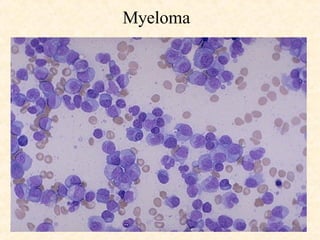
Myeloma

The document discusses malignant diseases of the lymphatic system and soft tissues, focusing on lymphomas and leukemias. It describes the classification, symptoms, diagnosis, staging, and treatment of both Hodgkin's lymphoma and non-Hodgkin's lymphomas. It also covers multiple myeloma and cutaneous T-cell lymphomas such as mycosis fungoides. The document contains many images illustrating the histopathology and clinical presentations of various lymphomas.

![Sarcoma – Risk Factors Occupational exposure (asbestos [pleural mesothelioma]; herbicides - Dioxin & Agent Orange; poly vinyl chloride-PVC- [causing hepatic angiosarcoma] ) Radiation (x-ray treatment, radiologists, dentists) 8x to 50x increase in incidence following radiation treatment, same area as radiation, different cell type, three year interval ) Chronic lymphedema (Lymphangiosarcoma in Stewart-Treves syndrome post radical mastectomy) Gene and chromosome abnormalities (Ewing’s sarcoma, clear cell sarcoma, myxoid liposarcoma, desmoplastic round cell sarcoma, Von Recklinghausen’s syndrome, Gardner’s syndrome, etc,)](https://image.slidesharecdn.com/malignant-diseases-lymphatics-soft-tissue-3-1215548258165094-9/85/Malignant-Diseases-Lymphatics-Soft-Tissue-3-54-320.jpg)































